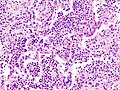

Aspiration pneumonia
Jump to navigation
Jump to search
Aspiration pneumonia is a type of pneumonia.
A special type of aspiration pneumonia is lipoid pneumonia. It is dealt with in the lipoid pneumonia article.
General
- Not associated with microorganisms - though empiric antibiotics are relatively common to cover infectious pneumonias that cannot be excluded easily on clinical grounds.[1]
- Usually seen in the context of a toxin and/or pathology that affects the swallowing and cough reflexes.[2]
Common associations:[2]
- Stroke.
- Multiple sclerosis.
- Alcohol intoxication.
Other risk factors:[1]
- Traumatic brain injury.
- Seizure disorder.
- Bowel obstruction.
- Drugs.
- Obesity.
- Labour.
Gross
- More common in the right lung.
- Right main stem bronchus is more vertical.
Microscopic
Features:
- Neutrophils.
- Foreign material, e.g. plant matter.
- +/-Foreign body giant cells.
- +/-Microorganisms.
DDx:
Images
See also
References
- ↑ 1.0 1.1 Raghavendran, K.; Nemzek, J.; Napolitano, LM.; Knight, PR. (Apr 2011). "Aspiration-induced lung injury.". Crit Care Med 39 (4): 818-26. doi:10.1097/CCM.0b013e31820a856b. PMID 21263315.
- ↑ 2.0 2.1 Ohrui, T. (Sep 2005). "Preventive strategies for aspiration pneumonia in elderly disabled persons.". Tohoku J Exp Med 207 (1): 3-12. PMID 16082150.